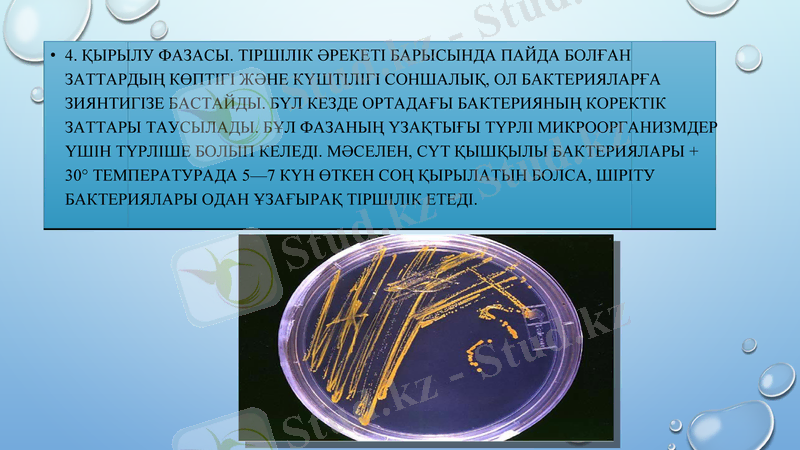
Slide 11

Бактериялардың морфологиясы, көбеюі және систематикасы



Бактериялардың көбеюі

Бактерия - біржасушалы, прокариоттарға жататын ұсақ организмдер. Алғаш рет бактерияларды ХVII ғасырда голланд ғалымы, микроскопты жасаушы - Антони ван Левенгук байқаған. 19 ғасырда бактериялардың құрылысы мен табиғаттағы рөлін француз ғалымы Луи Пастер, неміс ғалымы Роберт Кох және ағылшын ғалымы Джозеф Листер зерттеді.

Бактериялардың жасуша құрамында тұрақты жасуша қабаты, цитоплазмалық мембрана, цитоплазма, нуклеоид, рибосома болады. Ядроның қызметін дезоксирибонуклеин қышқылы (ДНҚ) атқарады.

Бактерия морфологиясы
Шар тәрізділер коккалар
Таяқша тәрізділер - бациллала р мен бактериялар
Иірілген немесе спираль тәрізділер - вибриондар, спириллалар және спирохеталар

Коккалар (көлденең өлшемі ұзындығына тең, яғни 0, 5 1, 5 мкм), тізбектеліп орналасқанда байланысқан орны жазық болуы мүмкін. Жеке жеке орналасса - микрококкалар; Қосқостан орналасса - диплококкалар; Төрттөрттен тіркескендері - тетракоккалар; Сегізсегізден текшеленгендері - Сарциналар; Моншақ тәрізді тізілгендері - стрептококкалар; Жүзім шоғыры тәріздестері - стафилококкалар деп аталады.

Бактериялар - спора түзбейтін таяқша тәрізді бактериялар
Бациллалар - спора түзетін таяқша тәрізді бактериялар .
Иректелген немесе спираль тәрізді бактериялар
Вибриондар - үтір тәріздес бактериялар
Спириллалар - бұйралана орналасқан бактериялар
Спирохета - ауру қоздырғыш, таяқша тәрізді бактерия

Бактериялардың көбеюі. Бактериялар бөліну арқылы көбейеді. Бөлшу кезінде клетканың ортасынан біртіндеп қалқанша пайда болып, клетка ішіндегі заттарды екіге бөледі Миксобактериялардың кейбір түрлерінде бұл байқалмайды. Егер таяқша тәрізді клеткалар бөлінгенде өз ара тең екі клетка пайда болса, оны изоморфты бөліну деп, керісінше, клетка бірдей тен, екіге бөлІнбей бөліктері әр түрлі болса-гетероморфты бөліну деп атайд. Бәлінудің соңғы түрі, ересек бактерияларда байқалады. Бактериялардың кебею жылдамдығы орта жағдайларына байланысты бо-лады. Егер Сбактерияларға қолайлы жағдай туса, олардың көбеюі де тездейді. Бактериялар үшін ортада қажетті қоректік заттар болып, жылу, ортаның реакциясы, аэробты бактериялар үшін оттегі жеткілікті болса, әрбір клетканың көбеюі 20-30 минут сайын қайталанып отырады. /Сондықтан көбею жылдамдығы мен сыртқы орта жағдайының арйсында тығыз байланыс, кейде тіпті тәуелділік бар деп те айтуға болады. Сөйтіп, азғана уакыт ішінде келемі 1-2 микрондай болатын бактериядан орасан көп клеткалар түзіледі.

Бактериялардың көбею жылдамдығын мына мысалдан айқын кә-руге болады. ІЕгер 20 минут сайын клетка бөлінетінін ескерсек, ол бір тәулік ішінде 72 рет қайталап 272=472-1019 клетка пайда бола-ды. Егер бір миллиард бактерия клеткасының салмағы 1 милли-грамдай болса, онда 472-1019 клетка 4720 тоннаға тең келеді.

Бактериялар бір жұма бойына бөлініп отырса, клеткалар саны да орасан көп болып, бүкіл жер шарын қаптап кеткен болар еді. Бірақ біз табиғаттағы мұндай құбылысты байқамаймыз. Өйткені пайда болған бактериялар клеткасының біразы сыртқы ортаның факторларының колайсыз әсерінен қырылып кетеді. Аман қалған бірер организм қолайлы ортаға түссе тез бө-лініп, жаңа ұрпақтар бере бастайды. Жіп тәрізді бактериялардың бөлінуі ерекше. Бүлар жіпшелерінен жеке вегетатив-тік - конидий немесе гонидий деп аталатын арнаулы клеткалар түзу арқылы көбейеді. Клеткалардьщ кейбір түрлері козғала алады. Оны зооспора-лар деп атайдьгі Ғылымда бактериялар көбеюінің бірнеше фазалары бел-гілі. Бүл микроорганизмдер тіршілігін баеқаруға мүмкіншілік береді.

1. Көбеюдің тежелу фазасы. Мүны лагфаза деп те атайды. Бүл фазада бактериялардын, көбеюі байқалмайды олар мұнда жаңа қоректік ортаға бейімделіп жатады. Бұл фаза 1-2 сағатқа созылады. Фазанын, аяқ шенінде клеткалар көбейе бастайды. Қоректік ортаға олардың әсері күшейе түседі. 2. Көбеюдің актив фазасы. Бұл кезеңде бактериялар қарқындап бөлінеді. Клеткалардың көбеюімен байланысты өсу жылдамдығы дарта түседі. Бұл екі сағаттай мерзімге созылады. 3. Стационарлық фаза. Қоректік ортадағы клеткалар саны ең көп мөлшерге жетіп, осы күйінде біраз уақыт тұрады. Көбеюдің осы фазасында тіршілік әрекеті нәтижесінде пайда болған заттар микроорганизмдердің көбеюін тежей бастайды. Клеткалардың көбею қарқыны баяулап, олардың біразы қырылып қалады. Сөйтіп жаңа пайда болған клетка саңы, елген клеткалар санына теңеледі. Бұл фаза бірнеше сағаттан бірнеше күнге созылады.
4. Қырылу фазасы. Тіршілік әрекеті барысында пайда болған заттардың көптігі және күштілігі соншалық, ол бактерияларға зиянтигізе бастайды. Бүл кезде ортадағы бактерияның коректік заттары таусылады. Бұл фазаның үзақтығы түрлі микроорганизмдер үшін түрліше болып келеді. Мәселен, сүт қышқылы бактериялары + 30° температурада 5-7 күн өткен соң қырылатын болса, шіріту бактериялары одан ұзағырақ тіршілік етеді.

- Іс жүргізу
- Автоматтандыру, Техника
- Алғашқы әскери дайындық
- Астрономия
- Ауыл шаруашылығы
- Банк ісі
- Бизнесті бағалау
- Биология
- Бухгалтерлік іс
- Валеология
- Ветеринария
- География
- Геология, Геофизика, Геодезия
- Дін
- Ет, сүт, шарап өнімдері
- Жалпы тарих
- Жер кадастрі, Жылжымайтын мүлік
- Журналистика
- Информатика
- Кеден ісі
- Маркетинг
- Математика, Геометрия
- Медицина
- Мемлекеттік басқару
- Менеджмент
- Мұнай, Газ
- Мұрағат ісі
- Мәдениеттану
- ОБЖ (Основы безопасности жизнедеятельности)
- Педагогика
- Полиграфия
- Психология
- Салық
- Саясаттану
- Сақтандыру
- Сертификаттау, стандарттау
- Социология, Демография
- Спорт
- Статистика
- Тілтану, Филология
- Тарихи тұлғалар
- Тау-кен ісі
- Транспорт
- Туризм
- Физика
- Философия
- Халықаралық қатынастар
- Химия
- Экология, Қоршаған ортаны қорғау
- Экономика
- Экономикалық география
- Электротехника
- Қазақстан тарихы
- Қаржы
- Құрылыс
- Құқық, Криминалистика
- Әдебиет
- Өнер, музыка
- Өнеркәсіп, Өндіріс
Қазақ тілінде жазылған рефераттар, курстық жұмыстар, дипломдық жұмыстар бойынша біздің қор #1 болып табылады.



Ақпарат
Қосымша
Email: info@stud.kz